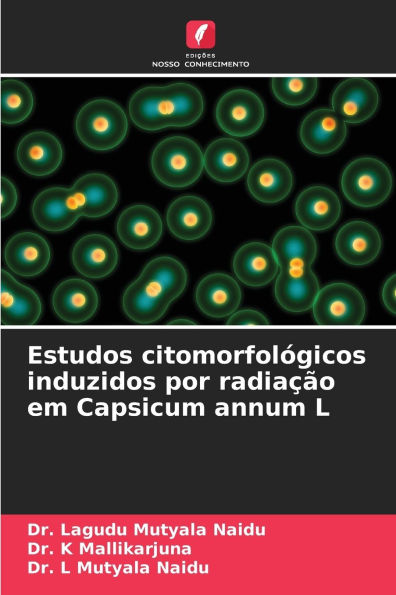
Estudos citomorfolï¿½gicos induzidos por radiaï¿½ï¿½o em Capsicum annum L

Home
Melhores procedimentos pedag�gicos para alcan�ar a automatiza��o em opera��es matem�ticas b�sicas
Barnes and Noble
Loading Inventory...
Melhores procedimentos pedag�gicos para alcan�ar a automatiza��o em opera��es matem�ticas b�sicas in Franklin, TN
Current price: $46.00

Barnes and Noble
Melhores procedimentos pedag�gicos para alcan�ar a automatiza��o em opera��es matem�ticas b�sicas in Franklin, TN
Current price: $46.00
Loading Inventory...
Size: OS
A incapacidade de aprender factos matemáticos básicos até atingir a automaticidade é o indicador mais comum de dificuldades em matemática. O Conselho Nacional de Professores de Matemática (NCTM) apoia o desenvolvimento da automaticidade em factos matemáticos a partir dos níveis do ensino básico. É necessário adquirir três níveis de conhecimento para alcançar a automatização em conceitos matemáticos básicos: conhecimento conceptual, procedural e declarativo. O conhecimento declarativo de conceitos matemáticos é alcançado quando os conceitos podem ser recuperados da memória sem hesitação. Este trabalho examina a base de investigação para o ensino que ajuda os alunos a alcançar o conhecimento declarativo em conceitos matemáticos básicos. Os componentes instrucionais eficazes incluem sistemas de entrega (ou seja, tutoria individualizada em proximidade, computadores e técnicas de tutoria entre pares), procedimentos instrucionais (ou seja, uso de estratégias, atraso constante e reapresentação de fatos perdidos) e técnicas de monitoramento do progresso (ou seja, tempo explícito e gráficos). Os dois programas que utilizam esses componentes, Mastering Math Facts e FASTT Math, também são descritos.
A incapacidade de aprender factos matemáticos básicos até atingir a automaticidade é o indicador mais comum de dificuldades em matemática. O Conselho Nacional de Professores de Matemática (NCTM) apoia o desenvolvimento da automaticidade em factos matemáticos a partir dos níveis do ensino básico. É necessário adquirir três níveis de conhecimento para alcançar a automatização em conceitos matemáticos básicos: conhecimento conceptual, procedural e declarativo. O conhecimento declarativo de conceitos matemáticos é alcançado quando os conceitos podem ser recuperados da memória sem hesitação. Este trabalho examina a base de investigação para o ensino que ajuda os alunos a alcançar o conhecimento declarativo em conceitos matemáticos básicos. Os componentes instrucionais eficazes incluem sistemas de entrega (ou seja, tutoria individualizada em proximidade, computadores e técnicas de tutoria entre pares), procedimentos instrucionais (ou seja, uso de estratégias, atraso constante e reapresentação de fatos perdidos) e técnicas de monitoramento do progresso (ou seja, tempo explícito e gráficos). Os dois programas que utilizam esses componentes, Mastering Math Facts e FASTT Math, também são descritos.